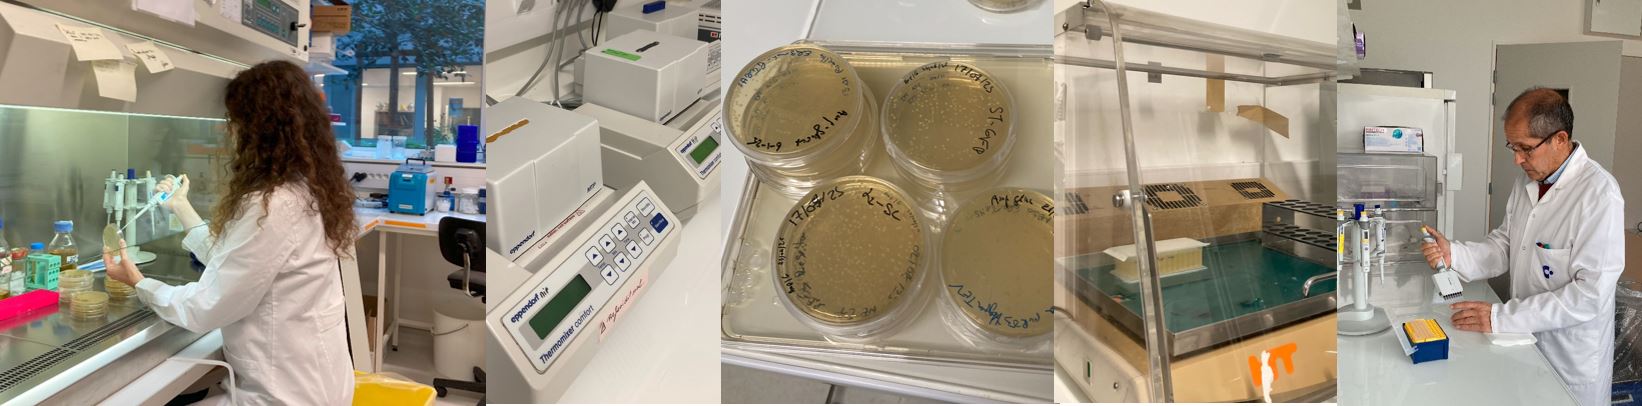

-
Quality of life - Health - Food
I2BC / ALPHAREP Platform
Technological platform
The ALPHAREP platform offers a custom selection service to identify alphaRep artificial proteins specific binders for any protein target of interest, using phage display technology.
The AlphaRep facility holds a large artificial proteins library (over one billion independent clones), designed to generate novel molecular recognition properties. These artificial proteins (named AlphaRep) can specifically bind their protein targets of interest with high affinities (KD from nM to µM). AlphaRep proteins are soluble, efficiently produced in E. coli, and extremely stable (Tm > 70°C), making them suitable tools for a variety of applications.
Expertise is focused on the development of tailored molecular binders with a wide range of applications. AlphaRep tools can provide protein engineering solutions in the following areas:
• Stabilization of specific protein partners
• Scaffolds for electron microscopy or crystallization
• Specific recognition units for cellular applications (eg antiviral nanoligands, intracellular recognition)
The AlphaRep facility holds a large artificial proteins library (over one billion independent clones), designed to generate novel molecular recognition properties. These artificial proteins (named AlphaRep) can specifically bind their protein targets of interest with high affinities (KD from nM to µM). AlphaRep proteins are soluble, efficiently produced in E. coli, and extremely stable (Tm > 70°C), making them suitable tools for a variety of applications.
Expertise is focused on the development of tailored molecular binders with a wide range of applications. AlphaRep tools can provide protein engineering solutions in the following areas:
• Stabilization of specific protein partners
• Scaffolds for electron microscopy or crystallization
• Specific recognition units for cellular applications (eg antiviral nanoligands, intracellular recognition)
Innovation themes
Affiliated laboratory
Av de la Terrasse
Campus CNRS - Bât 24 N1-Ouest
91198 Gif-sur-Yvette
Technologies utilisées
Several advanced techniques are employed for the development of molecular binders.• Phage display technology is used to select high-affinity specific binders from the alphaRep protein library.
• Library Screening: extensive screening experience is applied to identify and isolate among the selected alphaRep binders those with desired properties.
Keywords
Types de prestations
- R&D Collaboration
Offres de prestations
1- Phage display to select high-affinity ligands from the AlphaRep protein library (usually 3 rounds of selection). 2- Screening to identify and isolate the alphaRep proteins with the desired properties.
Establishments of affiliation


Département(s) de recherche
- SDV (Life sciences)
Certifications
- Other
Labellisations
- IBISA